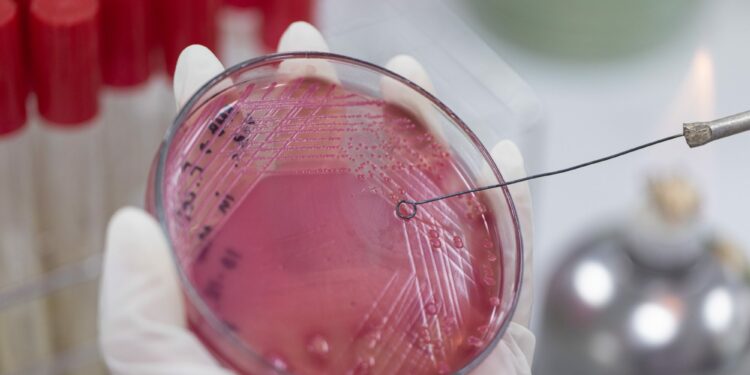
£210 million to Tackle Deadly Antimicrobial Resistance

State-of-the-art laboratories, cutting-edge disease surveillance systems, and a bigger global workforce to tackle deadly antimicrobial resistance (AMR) will be backed by up to £210 million of funding, the government has announced today. The funding – from the government’s UK aid budget – will support the Fleming Fund’s activities to tackle AMR in countries across Asia and Africa over the next three years, helping to reduce the threat it poses to the UK and globally.
Read More: Culture: New London Exhibition “Fuji”
It will bolster the surveillance capacity in up to 25 countries where the threat and burden of AMR is highest – including Indonesia, Ghana, Kenya, and Papua New Guinea – with more than 250 laboratories set to be upgraded and provided with state-of-the-art equipment. This investment includes new genome sequencing technology which will help track bacterial transmission between humans, animals and the environment.
The investment will also strengthen the international health workforce by supporting 20,000 training sessions for laboratory staff, pharmacists and hospital staff, and over 200 Fleming Fund scholarships to boost expertise in microbiology, AMR policy and One Health – which recognises the connection between humans, animals and the environment.
Read More: Nigeria’s Credit Rating Could Be Hurt By U.S.$7.5 Billion Loan
Around 1.27 million people around the world die each year due to AMR – where bacteria have evolved so much that antibiotics and other current treatments are no longer effective against infections – with one in five of those deaths in children under five. In 2019, AMR was found to have caused between 7,000 and 35,000 deaths in the UK alone.
The investment will deliver the second phase of the UK-India Fleming Fund partnership alongside India’s Ministry of Health and Family Welfare. Worth up to £3 million, it will accelerate collaboration on AMR surveillance across One Health sectors and help both countries to deliver on their 2030 roadmap.
Read More: Diving into Diversity –Afrilabs Pan-African Language Week 2023
As part of his visit to India, the Secretary of State will go to India’s National Centre for Disease Control, where India’s government and the Fleming Fund are joining forces to combat antimicrobial resistance.